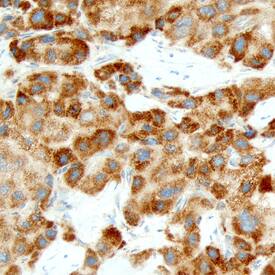
Carbonic Anhydrase VA/CA5A antibody in Human Liver by Immunohistochemistry (IHC-P).

Human Carbonic Anhydrase VA/CA5A Antibody
R&D Systems, part of Bio-Techne | Catalog # AF3049


Key Product Details
Species Reactivity
Applications
Label
Antibody Source
Product Specifications
Immunogen
Ala40-Ser305
Accession # P35218
Specificity
Clonality
Host
Isotype
Scientific Data Images for Human Carbonic Anhydrase VA/CA5A Antibody
Detection of Human Carbonic Anhydrase VA/CA5A by Western Blot.
Western blot shows lysates of HepG2 human hepatocellular carcinoma cell line. PVDF Membrane was probed with 1 µg/mL of Goat Anti-Human Carbonic Anhydrase VA/CA5A Antigen Affinity-purified Polyclonal Antibody (Catalog # AF3049) followed by HRP-conjugated Anti-Goat IgG Secondary Antibody (Catalog # HAF109). A specific band was detected for Carbonic Anhydrase VA/CA5A at approximately 33 kDa (as indicated). This experiment was conducted under reducing conditions and using Immunoblot Buffer Group 8.Carbonic Anhydrase VA/CA5A in Human Liver.
Carbonic Anhydrase VA/CA5A was detected in immersion fixed paraffin-embedded sections of human liver using Sheep Anti-Human Carbonic Anhydrase VA/CA5A Antigen Affinity-purified Polyclonal Antibody (Catalog # AF3049) at 10 µg/mL overnight at 4 °C. Before incubation with the primary antibody, tissue was subjected to heat-induced epitope retrieval using Antigen Retrieval Reagent-Basic (Catalog # CTS013). Tissue was stained using the Anti-Sheep HRP-DAB Cell & Tissue Staining Kit (brown; Catalog # CTS019) and counterstained with hematoxylin (blue). Specific staining was localized to hepatocyte cytoplasm. View our protocol for Chromogenic IHC Staining of Paraffin-embedded Tissue Sections.Applications for Human Carbonic Anhydrase VA/CA5A Antibody
Immunohistochemistry
Sample: Immersion fixed paraffin-embedded sections of human liver
Western Blot
Sample: HepG2 human hepatocellular carcinoma cell line
Formulation, Preparation, and Storage
Purification
Reconstitution
Formulation
Shipping
Stability & Storage
- 12 months from date of receipt, -20 to -70 °C as supplied.
- 1 month, 2 to 8 °C under sterile conditions after reconstitution.
- 6 months, -20 to -70 °C under sterile conditions after reconstitution.
Background: Carbonic Anhydrase VA/CA5A
Carbonic Anhydrase catalyzes the reversible reaction of CO2 + H2O = HCO3- + H+, which is fundamental to many processes such as respiration, renal tubular acidification and bone resorption (1). Topics in a CA meeting (6th International Conference on the CAs, June 20 - 25, 2003, Slovakia) ranged from the use of CAs as markers for tumor and hypoxia in the clinic, as a nutritional supplement in milk, and as a tool for CO2 removal and mosquito control in industry. Carbonic anhydrase VA encoded by the CA5A gene is a mitochondrial protein (2, 3). In comparison with another mitochondrial CA (CA5B), CA5A has different tissue distribution and chromosomal location (4, 5). Expression and inhibitor studies of different CAs in the rat pancreatic beta cells indicate that CA5A may be involved in the regulation of insulin secretion (6). CA5A may also participate in the detoxification of ammonia produced in the gastrointestinal tract by providing bicarbonate to carbamyl phosphate synthetase I (7). The amino acid sequence of recombinant human CA5A (residues 40 to 305) is 79%, 77%, and 76% identical to that of canine, bovine, and rat/mouse.
References
- Hewett-Emmett, D. and R.E. Tashian (1996) Mol. Phylogenet. Evol. 5:50.
- Nagao, Y. et al. (1993) Proc. Natl. Acad. Sci. USA 90:7623.
- Nagao, Y. et al. (1995) Genomics 28:477.
- Shah, G.N. et al. (2000) Proc. Natl. Acad. Sci. USA 97:1677.
- Fujikawa-Adachi, K. et al. (1999) J. Biol. Chem. 274:21228.
- Parkkila, A.K. et al. (1998) J. Biol. Chem. 273:24620.
- Saarnio, J. et al. (1999) J. Histochem. Cytochem. 47:517.
Alternate Names
Gene Symbol
UniProt
Additional Carbonic Anhydrase VA/CA5A Products
Product Documents for Human Carbonic Anhydrase VA/CA5A Antibody
Product Specific Notices for Human Carbonic Anhydrase VA/CA5A Antibody
For research use only